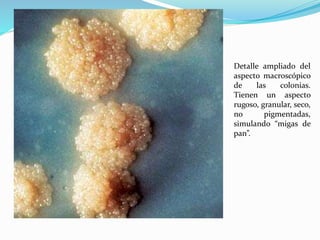
Detalle ampliado del
aspecto macroscópico
de las colonias.
Tienen un aspecto
rugoso, granular, seco,
no pigmentadas,
simulando “migas de
pan”.

1) El documento describe las características de Mycobacterium tuberculosis y las micobacterias. 2) M. tuberculosis causa la tuberculosis, una enfermedad importante para los humanos. 3) Los componentes de la pared celular de M. tuberculosis juegan un papel en la inmunopatogénesis de la tuberculosis y la respuesta inmune.